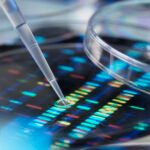

Test Epigenético

Ponemos a tu disposición los test epigenéticos de Epixlife. (Well Being y Vegano), con los que podrás poner a punto tu organismo.
La epigenética estudia la manera que tienen de expresarse nuestros genes.
La información que contiene el ADN se llama genotipo y es la misma para todas nuestras células.
Sin embargo, la expresión de esa información puede ser diferente según la célula, el estado en el que se encuentre u otros factores.
A esta expresión se le llama fenotipo.
La realización de un test epigenético puede ser beneficioso para ayudar a mejorar nuestros hábitos de vida.
la célula, haciendo que los genes se expresen o se mantengan inactivos.
¿Qué puedo esperar de este tipo de tests?:
- Se puede usar como medida preventiva como herramienta para evaluar el nivel de bienestar
- En caso de tener algún problema o desequilibrio, se puede usar para ayudar a mejorar de forma más eficiente.
- Conocer alimentos que son más o menos idóneos para ti en este momento o sensibilidades alimentarias
- Conocer si algún factor externo puede estar afectándote de forma negativa (ambientales, metales, humo, contaminación, radiofrecuencias…)
- Información para mejorar el equilibrio de tu microbiota
- Detectar carencias nutricionales
- Saber qué suplementos podrían ayudarte
- Información para trazar un plan de cambio de hábitos para corregir cualquiera de estos factores que nos pueden estar afectando.
- Ayudar a tener hábitos saludables para prevenir futuras enfermedades
- Retrasar el envejecimiento celular
- Mantener un peso saludable
¿Cómo se realiza este test?

Los test de Epixlife se realizan previa petición de cita, de una manera muy sencilla y nada molesta, solo requieren de la extracción con pinzas de 5 hebras de pelo de la persona que desea realizarse el test, idealmente cabello procedente de la nuca, con su raíz. Se revisa el bulbo del pelo y los resultados se analizan en los servidores de Cell Wellbeing en Alemania. Creamos un reporte personalizado con los resultados obtenidos y lo entregamos en formato digital.
Te daremos cita para la entrega e interpretación de los resultados y estrategia a seguir según tu caso.
Puedes ver más información detallada en este enlace.
*No sustituye a análisis sanguíneos, de ADN u otras muestras biológicas.
Pide tu cita previa en el teléfono de la consulta o whatsapp.
